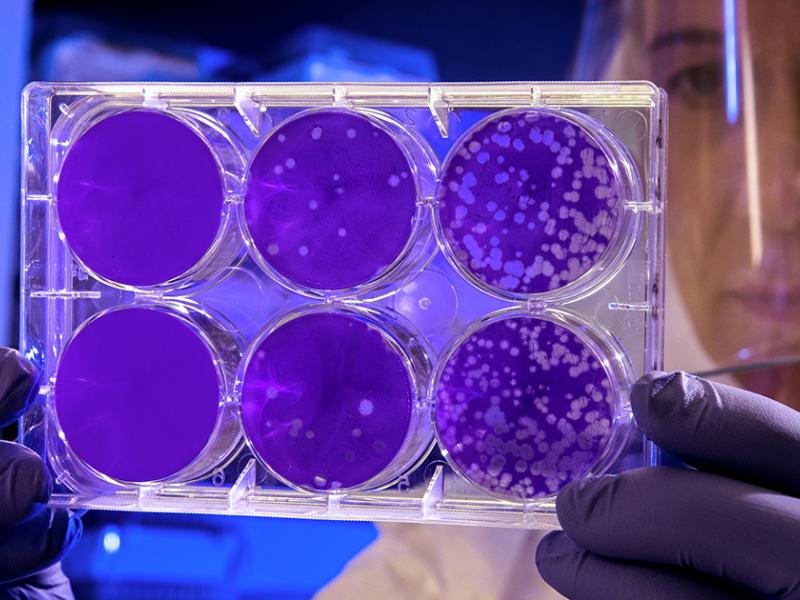
/media/aalto-ee-program-images/program-highlights-some-share-images/aalto-ee-patentit-teollisuus-tekniikka-some.jpg

Patentit-Teollisuus-Tekniikka - Teollisoikeuksien koulutusohjelma
Innovaatiosta syntyvä kilpailuetu kannattaa suojata. Keksintö on nopeasti kopioitu ja yrityksen etulyöntiasema menetetty, jos oivallukselle ei ole haettu patenttia tai muuta teollisoikeudellista suojaa.
Patentit–Teollisuus-Tekniikka -koulutusohjelma perehdyttää sinut teollisoikeuksiin ja sen aikana käydään läpi patentinhakuprosesseja Suomessa ja ulkomailla. Ohjelmassa painotetaan johdonmukaisen patenttitoiminnan merkitystä yrityksissä. Tutustut suomalaiseen ja eurooppalaiseen patenttijärjestelmään sekä muiden keskeisten talousalueiden tai maiden patenttijärjestelmien erityispiirteisiin, jotka kansainvälisesti toimivan yrityksen on tärkeä tuntea. Kuulet mahdollisuuksista ja keinoista ottaa parhaan hyödyn omista teollisoikeuksista ja siitä, miten välttää toisten teollisoikeuksien loukkaaminen. Ohjelma auttaa myös kehittämään patentteihin liittyvää liiketoimintaa ja luomaan immateriaalioikeuksiin liittyvää strategiaa.
Patentit-Teollisuus-Tekniikka -ohjelma tarjoaa mahdollisuuden suorittaa myös yksittäisiä opintojaksoja.
Suorittamalla tämän ohjelman olet oikeutettu alumnistatukseen ja pääset osaksi Aalto EE:n maailmanlaajuista alumniverkostoa. Alumniyhteisö tarjoaa arvokkaita etuja, jotka tukevat ammatillista kehittymistäsi ja verkostoitumistasi:
- Kutsuja eksklusiivisiin alumnitilaisuuksiin ja mahdollisuuden verkostoitumiseen muiden alumnien kanssa
- Alumniuutiskirjeen, joka kokoaa yhteen tärkeimmät uutiset, tapahtumat ja sisällöt
- Mahdollisuuden osallistua useimpiin ohjelmiimme alennettuun hintaan
Ohjelma avaa perinpohjaisesti koko patenttimaailman ja on patenttialan tärkein koulutus alan asiantuntijoille.
Ohjelma on patenttialalla erinomaisen tunnettu ja sen on ohjelman 35-vuotisen historian aikana suorittanut jo yli 900 osallistujaa.
2025 päättyneen ohjelmatoteutuksen osallistujien antama kokonaisarvosana ohjelmalle oli 5,0/6,0.
Hyödyt
Teollisoikeudet ja suojausmahdollisuudet tuntevan asiantuntijan avulla organisaatio suojaa keksintönsä ja valvoo oikeuksiaan myös Suomen markkinan ulkopuolella. Mitä paremmin asiantuntija tuntee teollisoikeuksia, sitä paremmin hän osaa valvoa yrityksen etua. Koulutus auttaa myös välttämään muiden oikeudenhaltijoiden teollisoikeuksien rikkomista ja/tai tukemaan asiakkaita edellä mainituissa toiminnoissa.
Kenelle?
Koulutusohjelma on kaikille, jotka hyötyvät työssään yrityksen teollisoikeudellisen kokonaisuuden hallitsemisesta: keksinnön syntymisestä sen suojaukseen ja hyödyntämiseen asti.
Koulutukseen on osallistunut esimerkiksi:
- yrityksissä pääasiallisesti teollisoikeudellisia asioita hoitavia patentti-insinöörejä
- patenttiasiamieheksi tähtääviä asiantuntijoita patenttiasiamiestoimistoista
- Patentti- ja rekisterihallituksen tutkijainsinöörejä
- yliopistoissa ja aluehallinnossa toimivia innovaatio- ja keksintöasiamiehiä
- tutkimuksen ja tuotekehityksen parissa työskenteleviä, jotka haluavat tuntea yleisesti keksintöjen suojaamisen periaatteet
- teollisoikeusasioita oman toimensa ohella hoitavia tai tehtävät pian vastuulleen ottavia
- teollisoikeuksien parissa työskenteleviä lakimiehiä.
Sisältö ja aikataulu
Ohjelma sisältää yhdeksän opintojaksoa (17 päivää). Opinnot koostuvat luennoista, keskusteluista ja ryhmätöistä, jotka auttavat sisäistämään ja soveltamaan koulutuspäivien antia.
Koulutusohjelman suorittamiseen kuuluu kolme osatenttiä ja harjoitustyö, joka on patenttihakemuksen laatiminen. Tämän lisäksi osallistuja voi halutessaan tehdä vapaaehtoisen erikoistyön/lopputyön.
Ohjelman kouluttajina ja luennoitsijoina on alan asiantuntijoita yrityksistä, patenttiasiamiestoimistoista, asianajotoimistoista ja Patentti- ja rekisterihallituksesta.
Patentit-Teollisuus-Tekniikka -ohjelma tarjoaa mahdollisuuden suorittaa myös yksittäisiä opintojaksoja.
Koulutusjaksot
Kustannukset ja ilmoittautuminen
Ilmoittautuminen yksittäisille opintojaksoille
Voit myös suorittaa yksittäisiä koulutusjaksoja Patentit-Teollisuus-Tekniikka -ohjelman kokonaisuudesta. Yhden jakso-osallistumisen hinta on 1 600 € (+ alv). Jaksokuvaukset näet ylempänä tällä samalla sivulla.
Hyödy hintaedusta kun samalla tilauksella on useita jakso-osallistumisia:
Kun valitset itsellesi useamman kuin yhden jakson, saat merkittävän hintaedun. Saat edun myös, jos organisaatiostasi ilmoittautuu kaksi tai useampi osallistuja samalle jaksolle.
- kaksi jakso-osallistumista 1 500 € (+ alv) / henkilö: yhteensä 3 000 € (+ alv)
- kolme jakso-osallistumista 1 400 € (+ alv) / henkilö: yhteensä 4 200 € (+ alv)
- neljä jakso-osallistumista 1 300 € (+ alv) / henkilö: yhteensä 5 100 € (+ alv)
- seuraavat jaksoilmoittautumiset + 1 300 € (+ alv) / henkilö
Kun lisäät tilaukselle yhden opintojakson, siirryt automaattisesti tilauslomakkeelle. Jos haluat lisätä tilaukselle myös muita jaksoja, palaa takaisin tälle sivulle ja lisää tilaukselle muut jaksot. Voit tilaussivulla jaksokohtaista tuotemäärää muuttamalla lisätä samalle jaksolle useamman kuin yhden osallistujapaikan.
Tämä koulutus käyttää Aalto EE:n uutta asiakastunnusta. Ennen kuin tilaat, lue lisää osoitteessa aaltoee.fi/asiakastunnus.